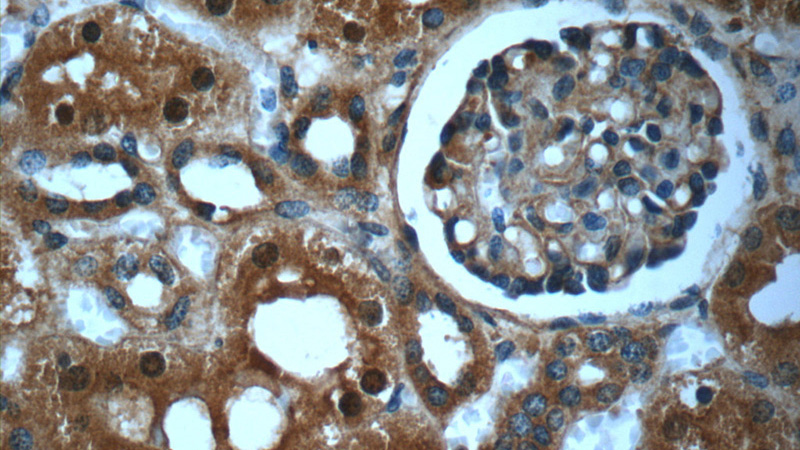
Immunohistochemistry of paraffin-embedded human kidney slide using Catalog No:113603(PAWR Antibody) at dilution of 1:50
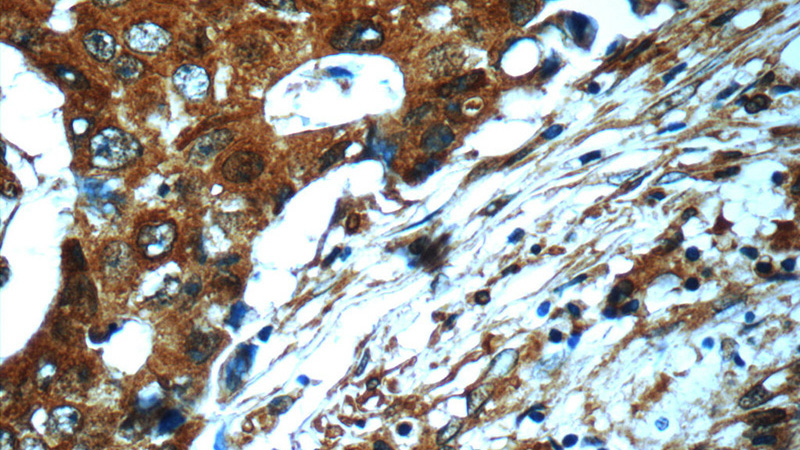
Immunohistochemistry of paraffin-embedded human breast cancer slide using Catalog No:113603(PAWR Antibody) at dilution of 1:50

-
Product Name
PAWR antibody
- Documents
-
Description
PAWR Rabbit Polyclonal antibody. Positive WB detected in mouse heart tissue, mouse kidney tissue. Positive IHC detected in human breast cancer tissue, human kidney tissue. Observed molecular weight by Western-blot: 45kd
-
Tested applications
ELISA, WB, IHC
-
Species reactivity
Human,Mouse,Rat; other species not tested.
-
Alternative names
Par 4 antibody; PAR4 antibody; PAWR antibody; Prostate apoptosis response 4 protein antibody
-
Isotype
Rabbit IgG
-
Preparation
This antibody was obtained by immunization of Peptide (Accession Number: NM_002583). Purification method: Antigen affinity purified.
-
Clonality
Polyclonal
-
Formulation
PBS with 0.02% sodium azide and 50% glycerol pH 7.3.
-
Storage instructions
Store at -20℃. DO NOT ALIQUOT
-
Applications
Recommended Dilution:
WB: 1:200-1:2000
IHC: 1:20-1:200
-
Validations

mouse heart tissue were subjected to SDS PAGE followed by western blot with Catalog No:113603(PAWR antibody) at dilution of 1:400
Immunohistochemistry of paraffin-embedded human kidney slide using Catalog No:113603(PAWR Antibody) at dilution of 1:50
Immunohistochemistry of paraffin-embedded human breast cancer slide using Catalog No:113603(PAWR Antibody) at dilution of 1:50
-
Background
PAWR, also named as PAR4, is a pro-apoptopic protein capable of selectively inducing apoptosis in cancer cells, sensitizing the cells to diverse apoptotic stimuli and causing regression of tumors in animal models. It induces apoptosis in certain cancer cells by activation of the Fas prodeath pathway and coparallel inhibition of NF-kappa-B transcriptional activity. PAWR inhibits the transcriptional activation and augments the transcriptional repression mediated by WT1. It down-regulates the anti-apoptotic protein BCL2 via its interaction with WT1. PAWR may be directly involved in regulating the amyloid precursor protein (APP) cleavage activity of BACE1. The antibody is specific to PAWR.
Related Products / Services
Please note: All products are "FOR RESEARCH USE ONLY AND ARE NOT INTENDED FOR DIAGNOSTIC OR THERAPEUTIC USE"
